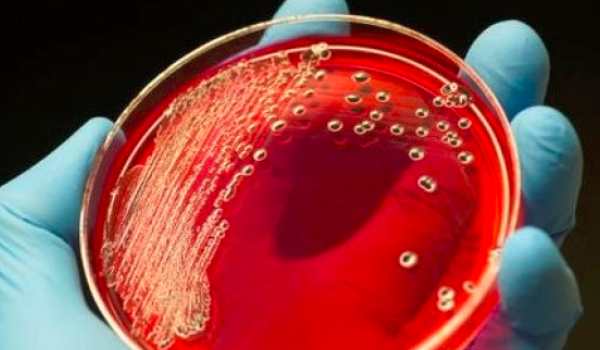

التهاب الدم: تعرف على أعراضه الخطيرة وأسباب تهديده للحياة
يُعد التهاب الدم أحد أخطر الحالات الطبية التي يمكن أن تصيب الإنسان، ويتطلب التدخل العاجل والعلاج السريع لمنع تفاقم الحالة وتهديد الحياة.
يعرف التهاب الدم علميًا باسم الإنتان (Sepsis)، ويطلق عليه أحيانًا تعفن الدم أو تسمم الدم (Septicemia).
ما هو التهاب الدم وأنواعه
يحدث التهاب الدم عندما تدخل الجراثيم إلى مجرى الدم، وقد تكون هذه الجراثيم بكتيرية، فيروسية، أو فطرية. يمكن أن تنتقل العدوى إلى الدم عبر الحقن، القسطرة، أو نقل الدم.
يؤدي الالتهاب إلى إطلاق الجسم لمواد كيميائية تسبب تفاعلًا التهابيًا ينتشر في الجسم ويؤذي الأعضاء المختلفة. تقسم مراحل التهاب الدم إلى ثلاثة:
1. المرحلة البسيطة (التهاب دموي بسيط)
2. الإنتان الحاد
3. الصدمة الإنتانية (Septic Shock)
الأعراض حسب المرحلة
أعراض التهاب الدم البسيط
ارتفاع درجة الحرارة فوق 38°م أو انخفاضها دون 36°م.
زيادة نبضات القلب لأكثر من 90 ضربة في الدقيقة.
زيادة معدل التنفس لأكثر من 20 نفسًا في الدقيقة.
ظهور علامات الالتهاب في الجسم.
أعراض تعفن الدم الحاد
يحتاج تشخيص الإنتان الحاد لوجود على الأقل عرضين من التالي:
بقع شاحبة على الجلد.
تغييرات في القدرات العقلية.
صعوبات في التنفس.
قلة التبول أو انخفاض كمية البول.
اضطرابات في ضربات القلب.
قشعريرة وانخفاض حرارة الجسم.
فقدان الوعي أو ضعف شديد.
أعراض الصدمة الإنتانية
تعتبر الصدمة الإنتانية أخطر مرحلة وقد تكون مهددة للحياة، وغالبًا ما تترافق مع أعراض تعفن الدم الحاد مع انخفاض ضغط الدم الحاد، ما يستدعي التوجه الفوري للطوارئ.
أسباب التهاب الدم وعوامل الخطر
يمكن لأي عدوى بكتيرية أو فيروسية أن تتطور لتصل إلى الدم، لكن أكثر الأسباب شيوعًا:
الالتهاب الرئوي.
التهابات الجهاز الهضمي.
التهابات المسالك البولية.
تلوث الدم البكتيري.
أما عوامل الخطر التي تزيد احتمالية الإصابة فتشمل:
كبار السن فوق 65 عامًا أو الأطفال دون سنة.
ضعف جهاز المناعة.
الإصابة بمرض السكري أو تليف الكبد.
التواجد الطويل في المستشفيات أو بعد إجراء عمليات جراحية.



